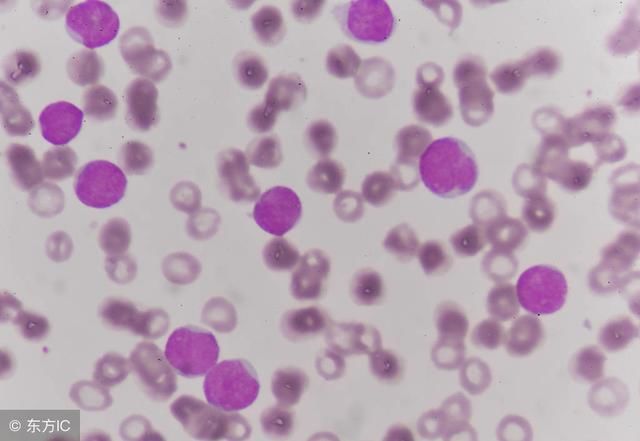
出现这些症状是白血病的前兆吗

白血病的四种前兆, 爸爸妈妈要注意了!
640x357 - 26KB - JPEG

这几种信号是血癌的早期征兆,家长要知道!
353x336 - 20KB - JPEG

孩子的这些症状,可能是白血病的前兆,妈妈们要
640x400 - 23KB - JPEG

这几种信号是血癌的早期征兆,家长要知道!
332x323 - 16KB - JPEG

这3种不适,家长们要注意了,可能是白血病的征
500x285 - 28KB - JPEG
不可忽视白血病的前期讯号高烧
640x427 - 35KB - JPEG

新房如果出现这2种症状, 及时搬离, 是白血病征兆
550x347 - 18KB - JPEG

六个隐形征兆竟暗示重病缠身 - 中国网福建
400x400 - 23KB - JPEG

这3种不适,家长们要注意了,可能是白血病的征
500x285 - 25KB - JPEG

要重视,孩子有这些表现很有可能是白血病的征
640x360 - 18KB - JPEG
出现这些症状是白血病的前兆吗
640x441 - 25KB - JPEG
警惕白血病的前兆是会出现高烧
553x342 - 12KB - JPEG

防癌| 这样发烧可能是癌症前兆
400x300 - 37KB - JPEG

宝宝要是出现这3种症状,可能是得了白血病的征
640x441 - 50KB - JPEG

大意,孩子的这几个症状可能是早期白血病的先
600x400 - 16KB - JPEG
健康咨询描述:反复发烧是白血病的以上是对“反复发烧是白血病的征兆吗”这个问题的建议,希望对您有帮助,
原标题:长期发烧或是白血病前兆 白血病的早期症状有哪些 不论是什么疾病在出现的时候,都是会有一个前兆
了,最近两个月经常发烧(半个月就烧一次),去医院医生做检查医生只是说喉咙我想请问这样会不会得白血病?
急性白血病的首发 症状多为发热,可表现为弛张热、稽留热、间歇热或不而白血病则不会)具体还是要检查的
对于患者来说,及时的发现白血病对之后的治疗是有着非常大的帮助的,那么,得白血病的前兆是什么?
病情描述:反复发烧 是白血病的征兆吗 看了该问题的网友还看了: 您好,白血病临床可表现有:(1)因成熟
那么到底什么是白血病?就不太对劲了,如果超过一周了还没有啥好转的话,并且还有出血、没力气的情况,啥也
都是会有一个前兆出现另外,医学界普遍认为,除了家族遗传,室内装修后带来的甲醛污染是儿童白血病的重要
问题描述:请问 高烧不退是白血病的前兆吗 病情分析:发热是一种现象,一般病情分析:白血病有发烧的症状。
长期发烧或是白血病前兆 白血病的早期症状有哪些:在现实生活中,白血病已经成为一种非常可怕的疾病,主要